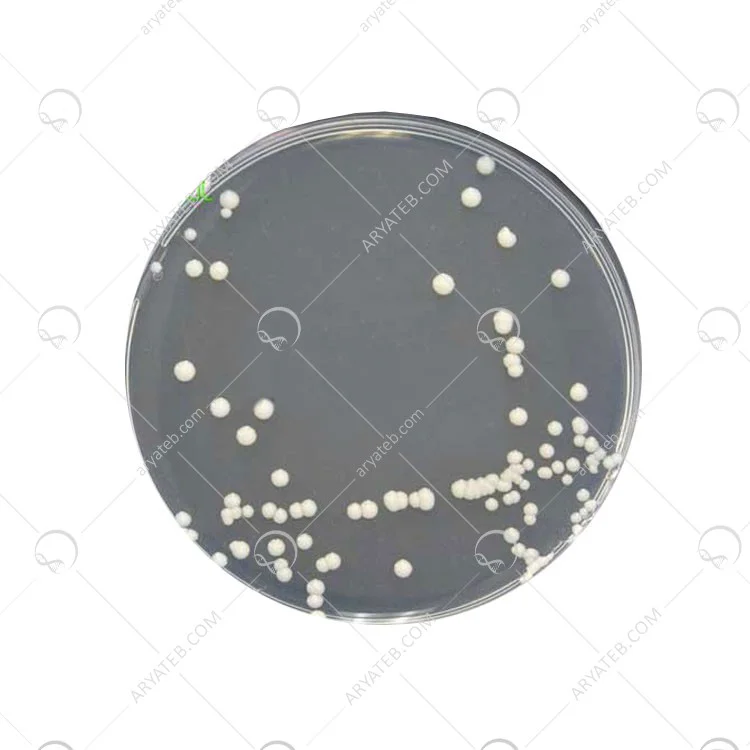

محیط کشت YGC agar
محیط کشت کلرامفنیکل آگار ابتدا توسط فدراسیون بین المللی لبنیات (IDF-IDF) ساخته و به بازار عرضه شد، اما بعداً مؤسسه دویچه وله نورمونگ (DIN) از این محیط کشت برای جداسازی و شمارش انتخابی مخمرها و کپک ها در شیر و محصولات لبنی استفاده کرد. در واقع می توان گفت که روش آنتی بیوتیکی برای شمارش مخمرها و کپک ها در لبنیات روش ارجح است زیرا منجر به بهبودی بهتر افراد آسیب دیده می شود.
عصاره مخمر منبع ویتامین ها به ویژه ویتامین های گروه B است که برای رشد باکتری ها ضروری است. دکستروز کربوهیدرات قابل تخمیر، دی اکسید کربن و کلرامفنیکل آنتی بیوتیکی است که به جداسازی قارچ های بیماری زا از مواد آلوده کمک می کند، زیرا به دلیل پایداری دما و طیف وسیعی از باکتری ها، باکتری های آلوده را بیشتر مهار می کند. آگار باکتریایی در این محیط کشت، از آگار به عنوان جامدکننده استفاده می شود.
اجزای تشکیل دهنده محیط کشت YGC Agar
.jpg)
طرز تهیه محیط کشت ygc
37.1 گرم از محیط کشت را در یک لیتر آب مقطر معلق کنید. خوب مخلوط کنید و با حرارت دادن با هم زدن مکرر حل کنید. به مدت یک دقیقه بجوشانید تا کاملا در اتوکلاو حل شود و در دمای 121 درجه سانتیگراد به مدت 15 دقیقه استریل کنید. تا 50 درجه سانتیگراد خنک کنید، خوب مخلوط کنید و روی بشقاب ها پخش کنید
نتیجه به دست آمده

کاربرد محیط کشت ygc
برای شمارش مخمر و قالب در محصولات شیر مطابق با ISO 6611
قیمت محیط کشت ygc
تیم متخصص فروشگاه تجهیزات و مواد آزمایشگاهی آریا طب همواره می کوشد تا با ارائه خدمات مناسب و مورد نیاز مشتریان همچون مشاوره خرید تجهیزات و مواد ازمایشگاهی، تجهیزات مطب ها و کلینیک ها و مواد آزمایشگاهی نیاز آن ها را به تجهیزات پزشکی مرتفع سازد پس چنانچه قصد خرید دستگاه اتوکلاو را دارید همین حالا با مشاوران ما تماس حاصل نمایید و تمامی سوالات و ابهامات خود را برطرف نمایید و سپس نسبت به خرید مناسب ترین ست اقدام نمایید. امروزه خرید آنلاین به دلیل های مختلفی همچون سرعت بالا، حذف هزینه رفت و آمد، عدم اتلاف وقت و ... دارای طرفداران بسیاری بوده و رواج گسترده ای پیدا کرده می باشد به همین دلیل مدیران آریا طب شرایطی را مهیا کرده اند تا خرید از این فروشگاه به صورت آنلاین نیز امکان پذیر باشد پس برای خرید به صورت اینترنتی به صفحه معرفی محصولات رفته و با انتخاب محصول مورد نظر و اضاف کردن آن به سبد خرید خود، فرم مربوطه را تکمیل نمایید سپس از طریق درگاه بانکی مربوطه هزینه آن را پرداخت کرده تا سفارش شما به مرحله ثبت نهایی برسد و همکاران ما در اسرع وقت آن را درب منزل یا محل کارتان به شما تحویل دهند.
آدرس ایمیل شما منتشر نخواهد شد. فیلدهای الزامی علامت گذاری شده اند *